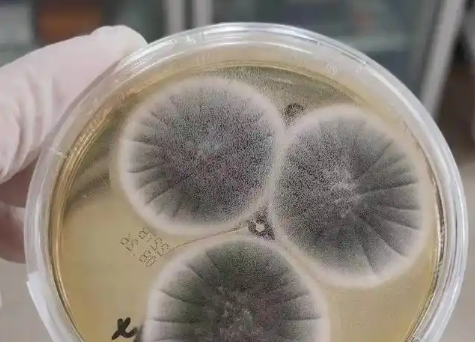

您好,欢迎来到贵阳金石合朋医院有限公司【官网】!咨询热线:0851-82270577
设为主页丨加入收藏


麻疹、水痘、手足口病,什..
- 麻疹、水痘、手足口病,什么时候容易传..
2026-04-10- 很多人有一种直觉:发烧最厉害的时候,应该也是传染性最强的时候。但在许多发热伴出疹的传染病中,真正的传播高峰往往在出疹前后。也就是说,当皮疹刚出现时,患者反而更容易把病原体传播给他人。这背后其实反映了.....
了解详情>>

关于心源性猝死,几个重点..
- 关于心源性猝死,几个重点问题要知道
2026-03-26- 心源性猝死又称心脏性猝死,是指急性症状发作后1小时内发生的以意识丧失为特征、由心脏原因引起的自然死亡,多发于器质性心脏病患者中,以冠心病及其并发症引起的猝死最为常见。 一、猝死为何会发生.....
了解详情>>

一个健康的身体,在春天应..
- 一个健康的身体,在春天应该注意那些问..
2026-03-26- 一、春天养生、身体方面 1. 防春寒、别太早脱衣服 春天气温忽冷忽热,“春捂秋冻”:重点护住头、颈、腰腹、脚踝。 早晚凉、中午热,出门多带一件薄外套。 2. 防过敏、鼻炎、花粉症 .....
了解详情>>

“万能”止痛药布洛芬,千..
- “万能”止痛药布洛芬,千万别乱吃!
2026-03-11- 生活中,头疼、牙疼、关节痛等各种疼痛时常找上门,很多人会下意识地掏出布洛芬来缓解。虽然布洛芬在镇痛领域属于“顶流”般的存在,但也有“短板”。布洛芬并不能应对所有疼痛,滥用还会带来健康风险。提.....
了解详情>>

牢记这5件小事,守护听力健..
- 牢记这5件小事,守护听力健康~
2026-03-11- 很多人存在一个误区:听力下降只是老年人的问题。事实上,长期戴耳机、熬夜、不当掏耳等日常习惯,都在悄悄损伤我们的听力。听力健康,从来都不是小事,却可以从小事做起。下面分享5件人人都能做到的护耳方法。 .....
了解详情>>

开学季,这些健康风险需重..
- 开学季,这些健康风险需重点防范→
2026-03-02- 寒假落幕,新学期启航,校园再次迎来学生们返校。回归集体生活、规律作息,是学生成长的重要环节,但人群聚集、作息调整、环境变化等因素,也会让多种健康风险随之上升。为保障学生身心健康、平稳适应校园生活,我.....
了解详情>>

危险性高的胸痛有何特点?..
- 危险性高的胸痛有何特点?出现这些情况..
2026-03-02- 发生胸痛的原因有很多,危险性高和危险性不高的都有。那么,有哪些表现需要警惕是危险性高的胸痛,一定要到医院就诊呢? 胸痛是多种疾病都可能产生的症状,危险性高的疾病包括急性心肌梗死、急性主.....
了解详情>>

女性经期需注意的问题?
- 女性经期需注意的问题?
2026-02-25- 注意事项 1.保温保暖: 不要凉水洗澡洗头 不能游泳——这个是一定要记住的 2.阴道操作: 经期不做手术 月经期不做妇科检查 禁止性生活 3.饮食禁忌: 忌.....
了解详情>>

雾化吸入治疗指南
- 雾化吸入治疗指南
2026-02-25- 为何选择要雾化? 起效快 雾化治疗是将药物通过呼吸吸入的方式进入呼吸道,直接送达肺部,通过肺泡吸收,从而达到无痛、迅速有效治疗的目的。 用药精准 在雾化吸入时,药液会.....
了解详情>>

皮肤感染科普小知识
- 皮肤感染科普小知识
2026-02-25- 皮肤感染需要及时处理,同时做好日常护理和预防措施。 1. 症状识别:留意皮肤是否出现红肿、疼痛、发热、化脓或渗液等情况,若有这些表现,可能提示皮肤感染。 2. 及时处理:一旦发现皮肤感染,不要.....
了解详情>>

酒精无效!诺如病毒防治重..
- 酒精无效!诺如病毒防治重点→
2026-02-03- 诺如病毒是引发急性胃肠炎的主要病原体之一,也是引起食源性暴发性胃肠炎最常见的病原体。诺如病毒一般在每年10月到次年3月高发,冷季流行更常见,全人群普遍易感,而且会重复感染。 一、表现:不同.....
了解详情>>

别不当回事!体检发现“脂..
- 别不当回事!体检发现“脂肪肝”了,怎..
2026-01-29- 有多少人翻开今年热乎的体检报告,“脂肪肝”三个字赫然在目?互相一打听,身边同事也有不少人中招。 它太常见了,常见到大部分人看到结果时,只是轻轻眉头一皱,“嗐,少吃点肉就好”,一番自我开解后,转.....
了解详情>>

黔ICP备2023011085号-1 黔ICP备2023011085号-2 贵阳金石合朋医院有限公司 网站直达号ID:1572
黔ICP备2023011085号-1 黔ICP备2023011085号-2 贵阳金石合朋医院有限公司 网站直达号ID:1572  关注微信公众号
关注微信公众号